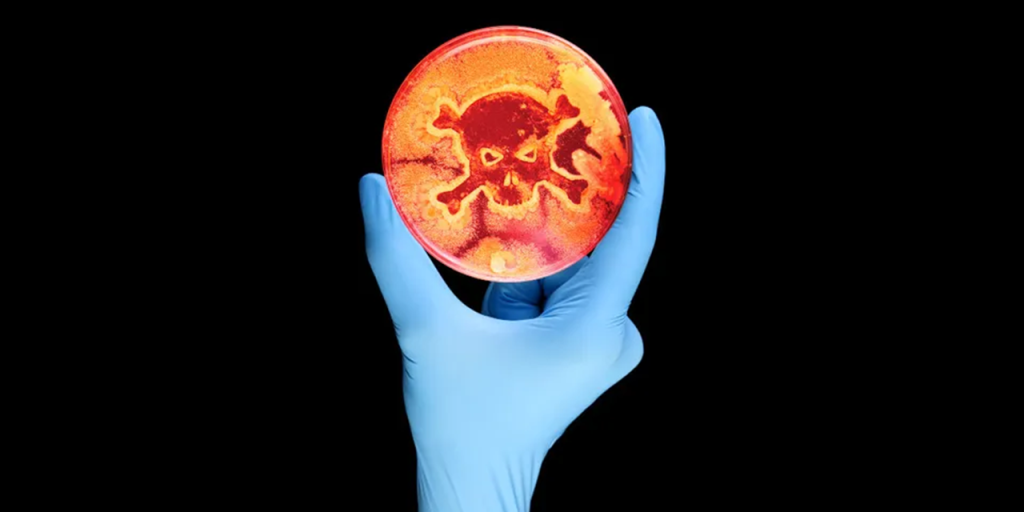

Scientists have shared more details about a severe and unusual E. coli outbreak that killed three people in France.
In January 2025, an outbreak of hemolytic uremic syndrome (HUS) in adults, caused by Shiga toxin–producing E. coli (STEC) was detected. HUS is a severe complication associated with E. coli infections that can cause kidney failure, brain damage and death.